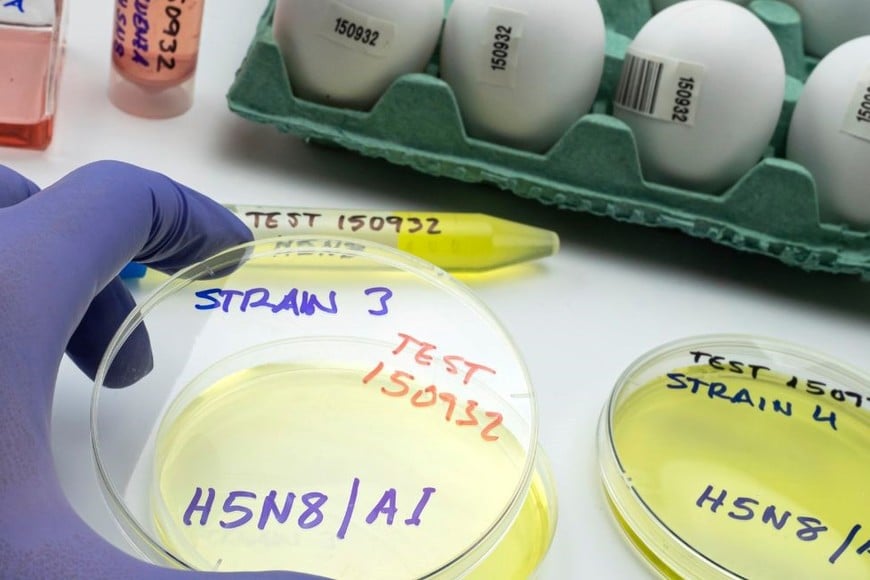
Muestras de suero para ser analizadas en laboratorios oficiales

En respuesta a la amenaza que representa la influenza aviar para la salud animal, la producción agropecuaria y la economía nacional, el Gobierno nacional oficializó nuevas medidas de control y prevención.

El Servicio Nacional de Sanidad y Calidad Agroalimentaria (Senasa) aprobó un plan de contingencia y fortaleció la vigilancia epidemiológica activa para prevenir y controlar brotes de influenza aviar en todo el país. Las medidas alcanzan tanto a productores avícolas como a criadores de aves de raza.

En respuesta a la amenaza que representa la influenza aviar para la salud animal, la producción agropecuaria y la economía nacional, el Gobierno nacional oficializó nuevas medidas de control y prevención.
A través de dos resoluciones publicadas en el Boletín Oficial, el Senasa aprobó un nuevo Plan de Contingencia contra la enfermedad y estableció la vigilancia epidemiológica obligatoria para aves de corral y de raza en todo el territorio argentino.
El 14 de febrero de 2023 se había confirmado el primer brote de influenza aviar altamente patógena (IAAP) en aves silvestres en Argentina. Desde entonces, se registraron múltiples casos en aves de corral, traspatio y silvestres, lo que motivó al Senasa a declarar la emergencia sanitaria.

Sin embargo, ahora, tras la estabilización de la situación epidemiológica, el organismo resolvió levantar tanto el estado de alerta preventiva como la emergencia sanitaria nacional.
La Resolución 466/2025 aprueba un nuevo Plan de Contingencia para la Influenza Aviar de tipo A subtipos H5 y H7, enfocado en actuar ante la sospecha o confirmación de brotes.
Este plan establece definiciones clave para la detección temprana, fija protocolos de actuación ante casos positivos y detalla medidas sanitarias específicas, como la interdicción de predios, el sacrificio sanitario y la limpieza y desinfección obligatorias.
También se establecen zonas de control sanitario, de perifoco y de vigilancia, con restricciones de movimiento para aves, huevos y productos derivados. Según el Senasa, mantener a la Argentina como país libre de influenza aviar es esencial para garantizar la producción avícola, proteger la salud pública y preservar los mercados internacionales.
Además, se faculta al organismo a disponer el sacrificio preventivo de aves en casos justificados, sin necesidad de confirmación de laboratorio, y se prevén indemnizaciones para los productores afectados. El incumplimiento de las nuevas normas será pasible de sanciones según la Ley 27.233.
En paralelo al plan de contingencia, el Senasa publicó la Resolución 468/2025, que incorpora al sector privado en el Programa Nacional de Vigilancia Epidemiológica Activa y Pasiva de Influenza Aviar y Enfermedad de Newcastle. Esta norma establece la obligatoriedad del muestreo serológico en todos los establecimientos con aves de corral y de raza del país.
La vigilancia activa se aplicará en gallinas ponedoras, pollos de engorde, aves reproductoras y aves de raza que participen en exposiciones o eventos. Dependiendo del tipo de establecimiento, se deberán tomar y enviar muestras de suero para ser analizadas en laboratorios oficiales dentro de plazos estrictos. El resultado negativo será requisito para autorizar movimientos de aves y productos.
Los veterinarios acreditados en sanidad y bienestar animal serán los encargados de realizar las extracciones, y los costos de los análisis estarán a cargo de los titulares de los establecimientos. En caso de incumplimiento, el Senasa podrá aplicar sanciones y bloquear el ingreso de aves a los predios mediante el Sistema Integrado de Gestión de Sanidad Animal (SIGSA).
Esta estrategia busca detectar de manera temprana posibles brotes y actuar rápidamente para evitar su propagación. Según explicaron desde el organismo, la vigilancia activa es clave para preservar el estatus sanitario nacional y sostener la expansión comercial de los productos avícolas argentinos, en especial en un contexto de crecimiento sostenido de la actividad.
Dejanos tu comentario
Los comentarios realizados son de exclusiva responsabilidad de sus autores y las consecuencias derivadas de ellos pueden ser pasibles de las sanciones legales que correspondan. Evitar comentarios ofensivos o que no respondan al tema abordado en la información.